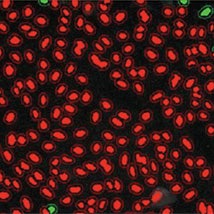
High nuclear translocation

Application Note
A Nuclear Translocation Screening Assay for ß-catenin modulators
- Reproducible phenotypic measurements
- High-throughput acquisition without compromising image quality
- Reduced analysis setup time with interactive data preview
- Unique statistical approach for robust measurement
Introduction
Bipolar disorder (BD) is a highly heritable psychiatric disorder that affects approximately 1% of the global population. First used to treat mania in 1949, lithium is still the most commonly prescribed treatment for BD. However in 50% of cases, patients do not respond positively to lithium treatment, and both toxicity and side effects remain a critical concern.
While the therapeutic basis of lithium’s mode of action is not completely understood, it is known to block the activity of Glycogen Synthase Kinase 3 (GSK-3) and to activate the Wnt signaling pathway, which directly and indirectly reduces proteasome-mediated degradation of ß-catenin. New protein and pharmacological regulators of Wnt/ß-catenin signaling can be identified based on their ability to block or unblock ß-catenin degradation, as measured by the amount of ß-catenin left to accumulate in the cell. Such quantitation can be streamlined through a high-throughput, systematic imaging approach for improved detection and analysis. To aid in this effort, a library of 1856 human-experienced compounds was screened by utilizing high-content screening platform in a cellbased reporter assay that allowed the measurement of ß-catenin accumulation in the nucleus in response to disruption of the Wnt signaling pathway.
Prepare end-point assays for high throughput workflow
U2OS cells, engineered to express human ß-catenin fused to enhanced green fluorescent protein (EGFP), were plated at 1500 cells/well in 384-well microplates. After cells were cultured for 48 hours at 37°C, compounds from the screening library were added. Cells were incubated for another 24 hours before they were fixed using 4% para-formaldehyde containing 5 μg/mL Hoechst 33342 DNA dye. Based on these results, one active compound from the screening library was further evaluated and shown below.
Image many cells for high statistical significance without compromising speed
High-content imaging was performed using the ImageXpress® Micro System. Four sites per well were acquired with a 10x objective using two wavelengths to measure EGFP fluorescence and Hoechst nuclear stain. The 10x magnification captured data on over 1000 cells in each field-of-view, consistently yielding statistically significant analysis results.

Identify phenotypic response to compound stimulation
Images of a ß-catenin-EGFP expressing cell line under basal conditions (control) showed no cytoplasmic or nuclear ß-catenin due to the constitutive proteasome-mediated degradation of the ß-catenin-EGFP reporter. Instead, images revealed a faint membranelocalized signal from interaction with a remaining subpopulation of cadherins in the cell membrane (Figure 2, left). Inhibition of the Wnt signaling pathway, for example with GSK-3ß inhibitors, caused a dose-dependent accumulation of the ß-catenin-EGFP reporter in the nucleus (Figure 2, right).

Figure 2. Zoomed images acquired using a 10x Plan Fluor objective. Response to normal Wnt expression, with fluorescent EGFP faintly visible and dispersed in cell membrane and no accumulation in cell nuclei (left). Upon treatment with GSK-3ß inhibitor, ß-Catenin-EGFP translocates into the nuclei due to inhibition of Wnt signaling (right).
Analyze data using interactive and flexible software
The Translocation-Enhanced Application Module of our MetaXpress® Software was used to identify the nucleus and quantify the amount of ß-catenin- EGFP fluorescence present in different compartments of the cells relative to the nucleus (Figure 3).

Figure 3. With the Translocation-Enhanced Application Module, a nuclear compartment is created from the nuclear stain and a cytoplasmic compartment is generated from the nuclear mask (top). The MetaXpress Software provides the freedom to adjust region measurements to define precise size and delineation between the compartments and to set a cutoff for scoring cells as positive or negative (bottom).
Segmentation of the nuclear compartment was generated from the area stained with Hoechst nuclear dye. This nuclear mask was then used with the second wavelength (EGFP) to create a compartment where its size and width can be adjusted according to the specifics of the assay. This allowed the fluorescence intensity within each compartment, such as nucleus, cytoplasm or cell membrane, to be quantified and analyzed. The interactive module gives instant feedback as parameters are adjusted, allowing analysis to be fine-tuned for each specific assay.
Our MetaXpress Software Translocation-Enhanced Application Module allows customization of how cells are scored using a variety of algorithms. In addition to measuring the average or total intensities of each wavelength in a particular cellular compartment on a per-cell or per-image basis, the Pearson’s correlation coefficient can be calculated from the intensities of the two stains in the entire cell region. The resulting coefficient ranges from -1 (anti-correlated) to 1 (perfectly correlated). In this instance, a higher coefficient signified more ß-catenin-EGFP had translocated to the nucleus (Figure 4).
Low nuclear translocation
High nuclear translocation

Figure 4: masks created in MetaXpress Segmentation Software for DMSO-treated negative control (left) and treated, MG132 positive control (right) conditions using the Translocation-Enhanced Application Module. In the images above, cells were scored positive (green) if they received a Pearson’s correlation coefficient of 0.5 or above and negative (red) if below 0.5.
Subsequently, dose-response curves were generated from plotting the ratio of nuclear compartment vs. cytoplasm mean intensity (Figure 5). Assay robustness was assessed by calculating the Z’ value.

Figure 5: Dose response curves for positive control compound MG132 (left) and sample hit Compound A (right). By plotting the ratio of the nuclear compartment:cytoplasm mean intensity, IC50 values were determined. Robustness of the assay is demonstrated by a calculated Z’ value greater than 0.7 from the MG132 positive control.
Measure translocation events in a high-throughput manner
This assay, which measures ß-catenin translocation in response to compounds that modulate its signaling pathways, is one example of a high-throughput assay for detecting intracellular translocation events. High quality images, even at low magnification, resulted in statistically relevant measurements for characterizing compound activities and clearly identified active compounds from the multitude assayed. Pairing a cell-based reporter gene assay with our high-content screening platform provides the complete solution for a successful screening campaign for translocation of proteins from one cell compartment to another.
Learn more about ImageXpress Micro >>